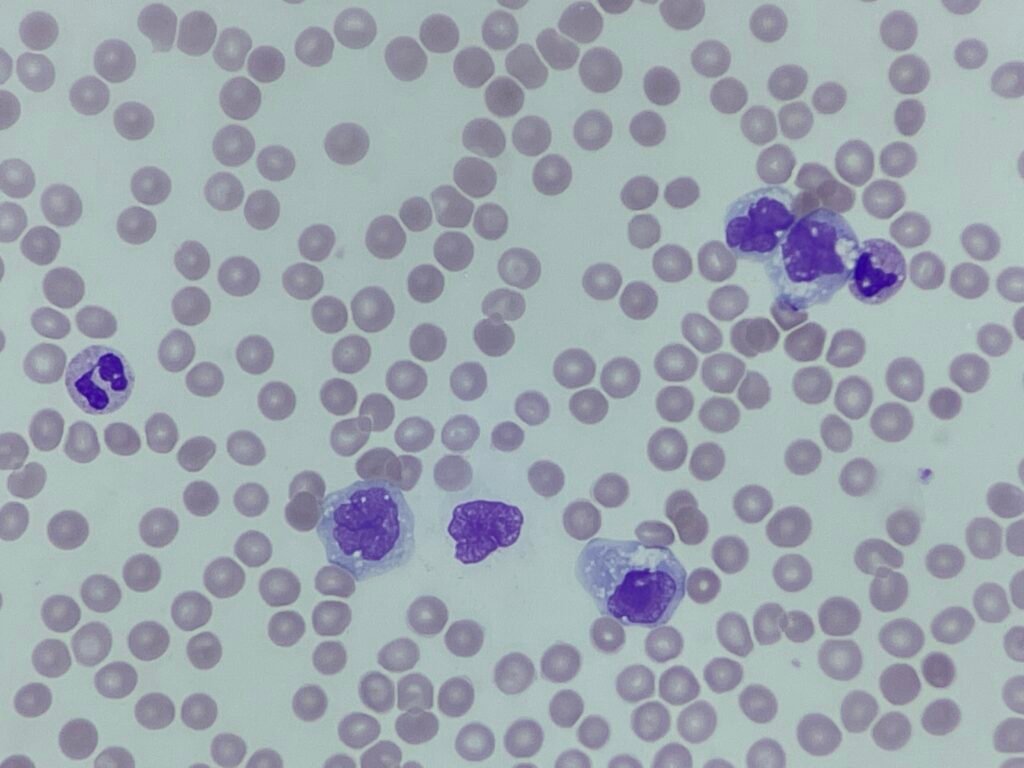
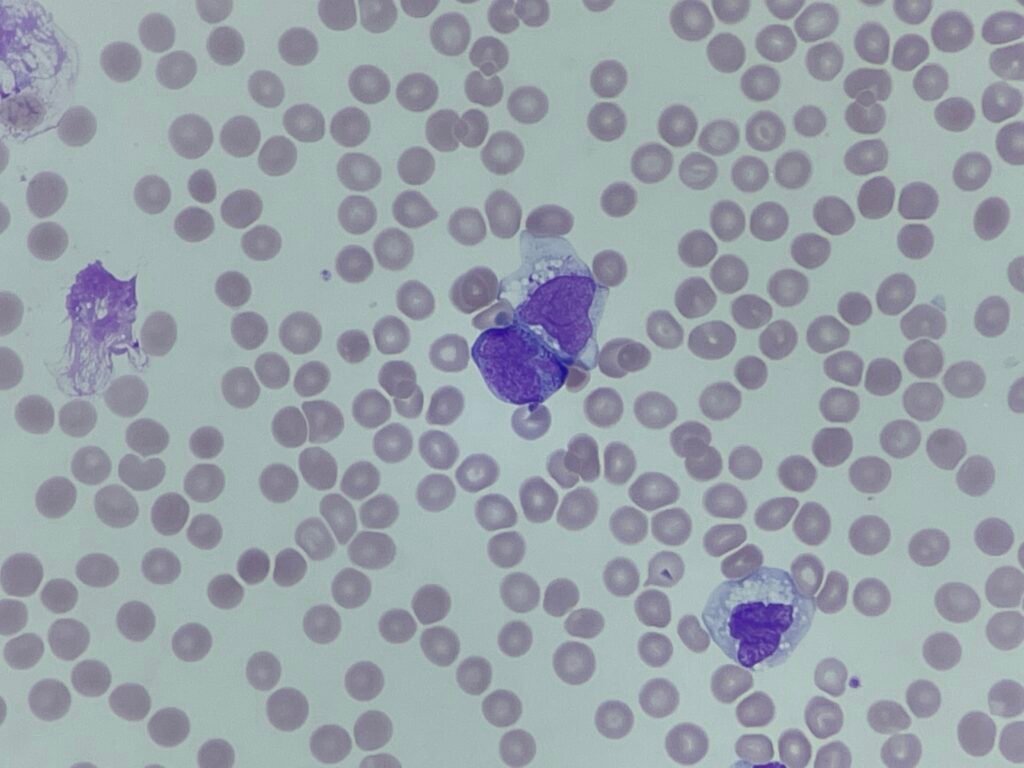
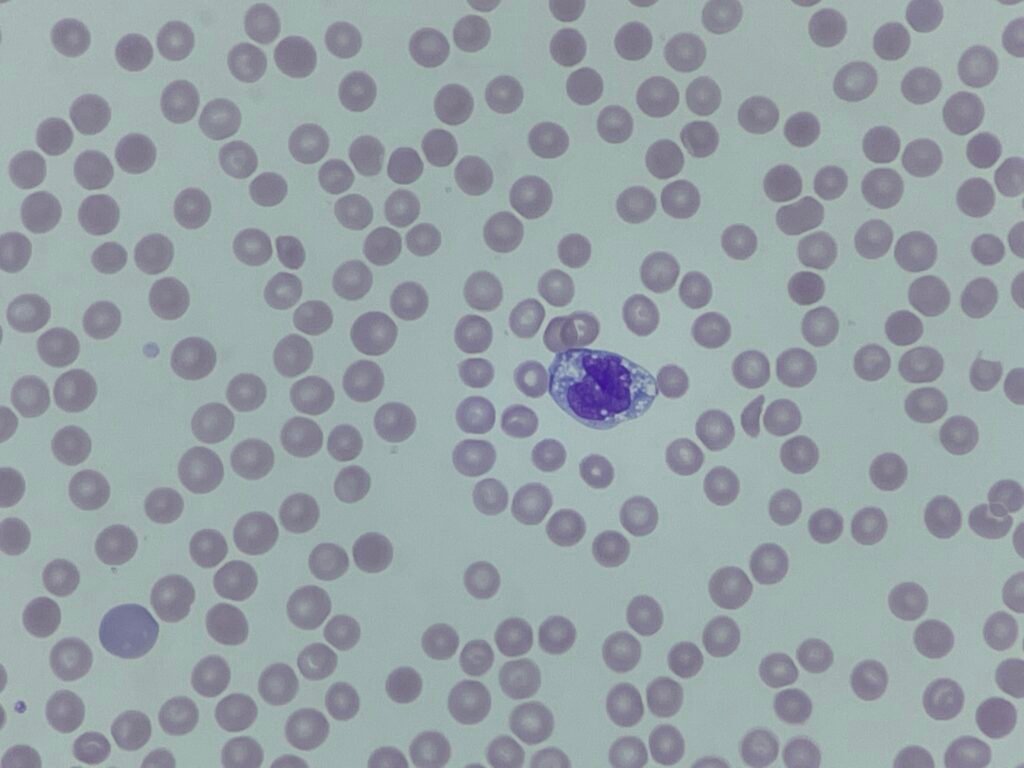
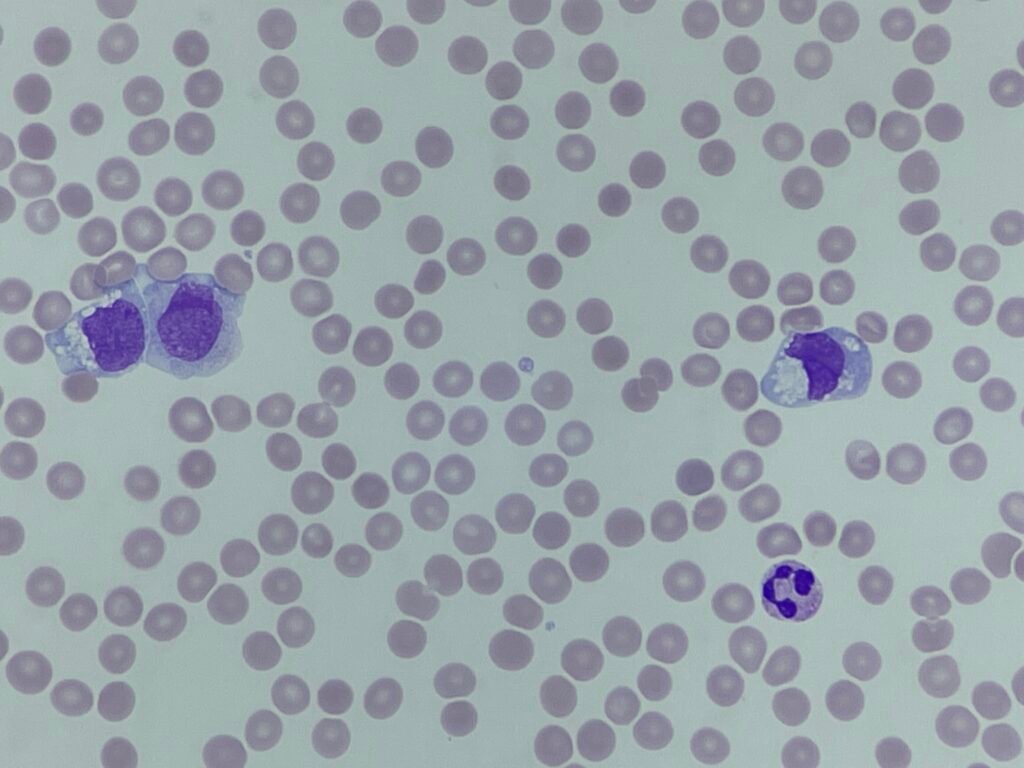
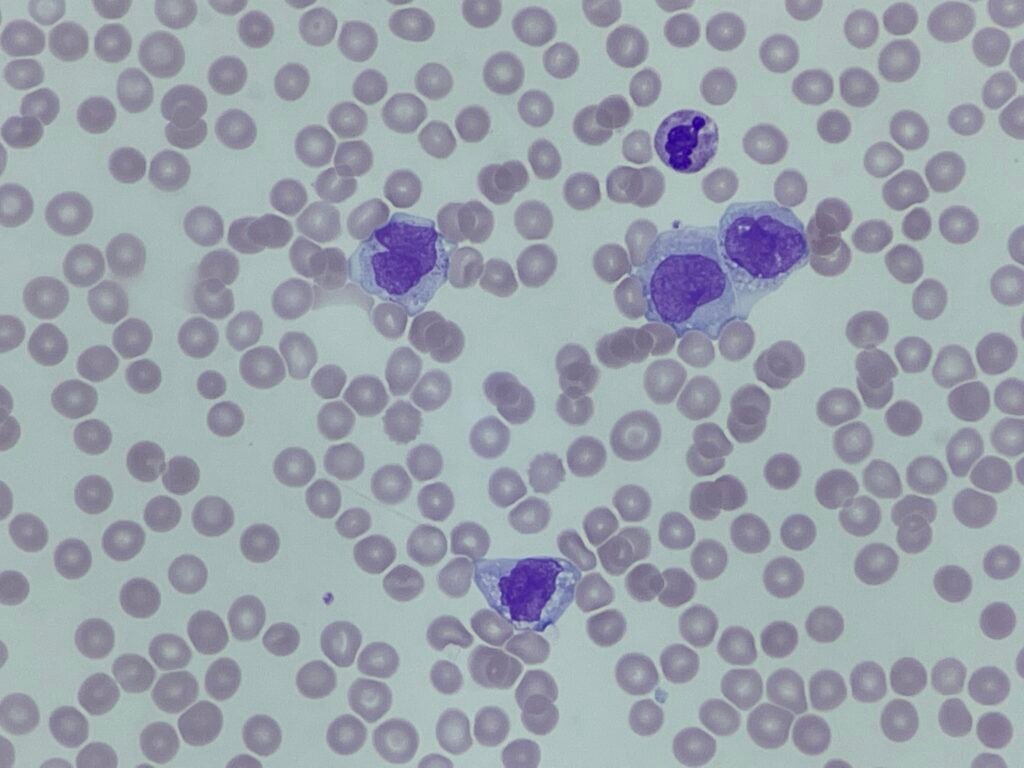

This week we have a case from a 61-year-old patient who presented with persistent fatigue and unintentional weight loss. Routine bloods were performed, and the full blood count has raised some important red flags.
Full blood count results:
- WBC: 50.4 × 10⁹/L
- RBC: 2.96 × 10¹²/L
- Hb: 84 g/L
- HCT: 0.245
- MCV: 91.5 fL
- MCH: 28.4 pg
- MCHC: 339 g/L
- RDW: 15.2%
- Platelets: 122 × 10⁹/L
The analyser also generated abnormal scattergram flags and a blast flag, prompting a manual differential and film review.

The sample was sent for flow cytometry. Here is a summary of the immunophenotype results:
| Marker | Expression |
| CD45 | Dim–moderate |
| CD34 | Negative |
| CD117 | Variable weak |
| HLA-DR | Positive |
| CD13 | Positive |
| CD33 | Strongly Positive |
| CD14 | Positive in a subset |
| CD64 | Stronly Positive |
| CD36 | Positive |
| CD11b | Positive |
| CD15 | Variable |
| CD16 | Negative |
| CD56 | Negative |
| CD7 | Negative |
| CD19 | Negative |
There’s quite a lot going on here. What stands out to you at first glance? Drop your initial thoughts below.
As always you can also follow the case on LinkedIn and Twitter/X.
5 Comments
Acute monocytic leukemia
What makes you say it’s acute? Lots of monocytes around…
Chronic myelomonocytic leukemia
Chronic Myelomonocytic leukemia
Lmmc